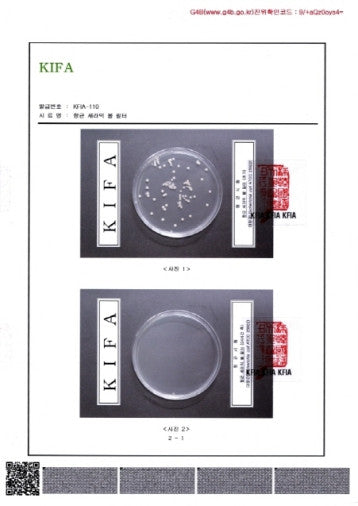

Jūs negalėsite palyginti daugiau nei 4 produktų vienu metu
Žiūrėti palyginimąTyrimai ir plėtra (R&D)
Mes nuolat investuojame į naujus modelius bei pažangias technologijas, siekdami tapti pirmaujančiu pasauliniu aukščiausios kokybės dušo galvučių gamintoju. KNTec tyrimų ir plėtros (R&D) centras tiria vandens svarbą bei jo poveikį odos sveikatai, kad kiekvienas galėtų mėgautis patobulinta, malonia ir sveikesne dušo patirtimi.

Inovacijos bei vandens vertė
Nuo pat įkūrimo 1999 metais, bendrovė kryptingai dirba vandens taupymo, vitaminu C praturtintų dušo galvučių, maišytuvų su aromaterapiniais filtrais ir kitų sveikatą tausojančių sprendimų srityse. Nuolat tobulindami savo produktus bei procesuose taikydami mokslinius tyrimus, sėkmingai plečiamės į tarptautines rinkas ir siekiame užtikrinti nepriekaištingą kokybę bei novatorišką dizainą.
-

Oficialūs sertifikatai
KNTec R&D centras veikia pagal sertifikuotas kokybės sistemas (ISO 9001, ES RoHS, CE ir kt.), leidžiančias užtikrinti aukštus gamybos ir produktų patikimumo standartus. Atliekami išsamūs testai: vandens taupymo efektyvumas, dušo galvučių tarnavimo laikas, chloro šalinimo lygis ir kiti svarbūs tyrimai. Bendradarbiaudami su įvairiomis tarptautinėmis organizacijomis, užsitarnavome reputaciją kaip patikimas premium klasės dušo įrangos gamintojas.
-

Dizaino ir patirties plėtra
Kasmet pristatome naujus dušo galvučių ir maišytuvų modelius, atsižvelgdami ne tik į technines savybes, bet ir į vartotojų patirtį. Reguliariai rengiame konferencijas, kad išsiaiškintume klientų poreikius bei naujausias tendencijas, o tada jas pritaikome savo kuriamuose produktuose. Tokiu būdu siekiame pasiūlyti ne tik išskirtinę vandens taupymo ir aromaterapijos technologiją, bet ir modernų, šiuolaikišką dizainą.
Inovacijos, kurias saugo patentai
Mūsų dušo galvutės technologija, filtrai irdizainai yra oficialiai patentuoti bei registruoti Pietų Korėjoje. Tai –kokybės, originalumo ir mokslinio pagrįstumo garantija

Siekis kurti vertę pirkėjui
Kurdami premium klasės dušo galvutes bei maišytuvus, visuomet orientuojamės į pirkėjų naudą:
- Vandens bei energijos taupymas.
- Sveikatai palankūs sprendimai (pvz., vitaminu C praturtintos kapsulės).
- Maloni vartotojo patirtis ir prabangos pojūtis kasdieniame rituale.
Nuolat ieškome naujų būdų, kaip pagerinti dušo ir vandens naudojimo potyrį, kad aromica.lt klientai galėtų mėgautis aukščiausios kokybės sprendimais savo namuose ir už jų ribų. KNTec R&D centras neapsiriboja vien tik gamyba – mes siekiame prisidėti prie geresnės vandens naudojimo ateities ir skleidžiame žinią apie vandens tausojimo bei odos sveikatos naudą kiekviename žingsnyje.
Pateiktos paraiškos registruoti Water Lab ir Aromica prekės ženklus.
Pateiktos paraiškos registruoti LAB800 ir LAB900 gaminių dizainus.
Sukurtas sudėtingas dušo galvučių kasetės sprendimas.kurtos Suany dušo galvutės.